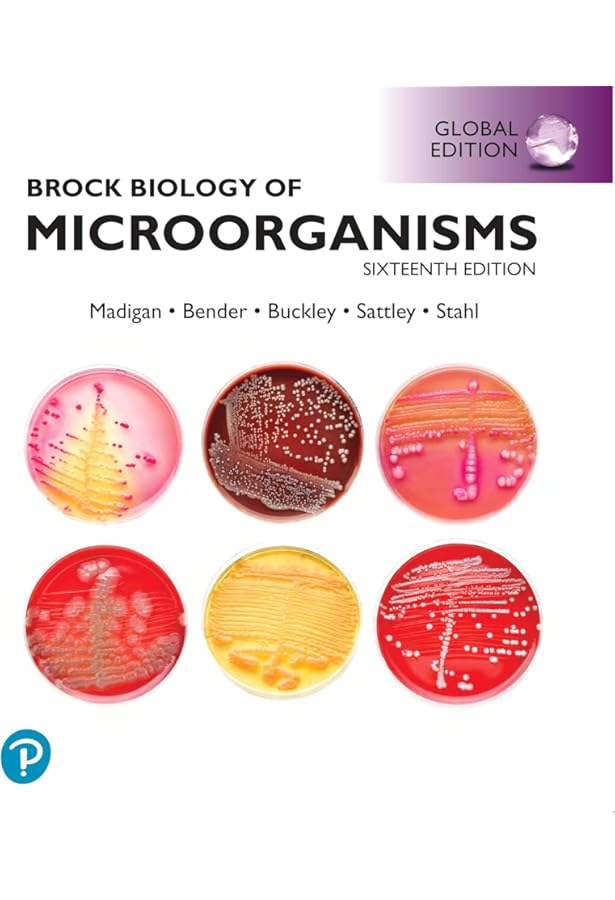

マイストア
変更
お店で受け取る
(送料無料)
配送する
納期目安:
08月08日頃のお届け予定です。
決済方法が、クレジット、代金引換の場合に限ります。その他の決済方法の場合はこちらをご確認ください。
※土・日・祝日の注文の場合や在庫状況によって、商品のお届けにお時間をいただく場合がございます。
新しいエルメス Brock微生物学 メルカリ - 語学+参考書の詳細情報
Brock微生物学 - メルカリ。WebOPAC Local書誌詳細。Rps14 haploinsufficiency causes a block in erythroid。
商品説明
【30日間返品保証】
fendo-13-846154-g007.jpg
商品説明に誤りがある場合は、無条件で弊社送料負担で商品到着後30日間返品を承ります。
民事書記官事務の解説―第一審訴訟記録に基づいて 裁判所職員総合研修所
MFCプログラミング (アスキーアジソンウェスレイシリーズ) Alan R.Feuer、 ロングテール; 長尾 高弘
【最短翌日到着】
頭・頸部の筋の形と位置: 立体的イメージングのために
正午12時まで(日曜日は午前9時まで)の注文は当日発送(土日祝も発送)。関東・関西・中部・中国・四国・九州地方は翌日お届け、東北地方・新潟県・北海道・沖縄県は翌々日にお届けします。
画像検査診断用語事典―サイン・画像所見・症候群・検査用語 [単行本] 楢林勇; 中尾宣夫
Modern Military Strategy [ペーパーバック] Sloan, Elinor C.
【インボイス制度対応済み】
眼鏡&コンタクトレンズの合わせかた: 67の屈折矯正で知る・学ぶ・鍛える (眼科ケア2013年夏季増刊) [単行本] 佐野 研二; 河賀 友紀
当社ではインボイス制度に対応した適格請求書発行事業者番号(通称:T番号・登録番号)を印字した納品書(明細書)を商品に同梱してお送りしております。こちらをご利用いただくことで、税務申告時や確定申告時に消費税額控除を受けることが可能になります。
古文全天候バイブル 吉川 栄治
憲法I [第3版] 法律学全集3 清宮 四郎
ご満足のいく取引となるよう精一杯対応させていただきます。
Principles of Exercise Testing and Interpretation,Wasserman MD PhD,Karlman、 Hansen MD,James E.、 Sue MD,Darryl Y.、 Stringer MD,William W.、 Sietsema MD,Kathy E.、 Sun MD,Xing-Guo; Whipp PhD DSc,Brian J
Photoshop 4.0Jびっくりロゴデザイン
※下記に商品説明およびコンディション詳細、出荷予定・配送方法・お届けまでの期間について記載しています。ご確認の上ご購入ください。
平成27年版 体系別 司法試験・予備試験 短答 過去問集 刑法 スクール東京; 豊彦,成川
ハンセン病違憲国賠裁判全史 [単行本] ハンセン病違憲国賠裁判全史編集委員会
■商品名■
膀胱の手術 (新Urologic Surgeryシリーズ 2) 中川 昌之
Brock微生物学
語学+参考書 Constructionalization and Constructional Changes (Oxford Studies in Diachronic and Historical Linguistics)
みんなが欲しかった 簿記の教科書 日商2級 工業簿記 第7版対応DVD (TAC出版) (みんなが欲しかったシリーズ) TAC出版編集部
■出版社■
外国人技能実習生受入れ実践ガイド――入管手続と協同組合作り [単行本(ソフトカバー)] 岸本 和博
オーム社
口腔病理カラ-アトラス 石川梧朗
スマートナース 11巻3号
■著者■
エッセンシャル遺伝学・ゲノム科学(原著第7版)
Brock
数学1・A2・B (2004) (河合塾シリーズ)
語学+参考書 Mechanics: Volume 1
■発行年■
食品学各論(第3版): 食品素材と加工学の基礎を学ぶ 瀬口 正晴; 八田 一
2003/04/15
テキスト裁断済み 河合塾 2019・2020 冬期講習 東大物理 苑田尚之先生
アンズワールド ディズニー英語システムDWE
■ISBN10■
Attachment in Psychotherapy [ペーパーバック] Wallin,David J.
4274024881
Lucknow: The City of Heritage & Culture: a Walk Through History [ハードカバー] Varshney,Vipul B.; Jaiswal,Ajaish
歯科衛生士臨床のすべて―経験から学ぶ臨床 (quintessence books) AntonellaTani Botticelli、 浩,岡本、 愉,関野、 泰子,竹内; 由香里,星野
■ISBN13■
金沢医科大学 2020年度 (医学部入試問題と解答) [単行本] みすず学苑中央教育研究所
9784274024887
安全な内視鏡外科手術のための基本手技トレーニング [単行本] 橋爪誠; 富川盛雅
語学+参考書 Recursive Methods in Economic Dynamics
■コンディションランク■
芝浦工業大学柏高等学校 2020年度用 (高校別入試過去問題シリーズ C9) 東京学参 編集部
可
HOW TO 審美と歯周外科 (クリニカル・テクニック・シリーズ) [単行本] 伊藤 公一
診療画像検査法X線撮影法
コンディションランク説明
間脳下垂体 (脳神経外科エキスパ-ト) 佐伯直勝
ほぼ新品:未使用に近い状態の商品
ペインクリニックに必要な局所解剖 麻酔科診療プラクティス (12) 真弓,高崎
非常に良い:傷や汚れが少なくきれいな状態の商品
整形外科のMRI 秀繁,守屋; 宏,北原
良い:多少の傷や汚れがあるが、概ね良好な状態の商品(中古品として並の状態の商品)
国際私法年報 第21号(2019) [単行本] 村上愛 、 駒田 泰土、 阿部 耕一、 小塚 荘一郎、 中村 知里、 金 美和、 不破 茂; 国際私法学会
可:傷や汚れが目立つものの、使用には問題ない状態の商品
ショック管理 2021-’22 (救急・集中治療33巻3号) [単行本] 垣花泰之
大学への数学入試の軌跡東工大10年間・理科大3年間 2002 (軌跡シリーズ)
■コンディション詳細■
SAPIX 小3 サピックス 算数基礎力トレーニング 【計12回分】 通年セット 2020 ☆ 035M2D
当商品はコンディション「可」の商品となります。多少の書き込みが有る場合や使用感、傷み、汚れ、記名・押印の消し跡・切り取り跡、箱・カバー欠品などがある場合もございますが、使用には問題のない状態です。水濡れ防止梱包の上、迅速丁寧に発送させていただきます。
西大和学園中の理科20年 2023年度受験用 赤本 1915 (難関中学シリーズ)
小児歯科学 赤坂 守人
SAPIX サピックス 6年 社会
■当社の出品一覧↓■
浜学園 小6 第563〜573回 公開学力テスト 国語/算数/理科/社会 テスト計11回分セット 2020 ☆ 057M2D
#ブックスドリーム出品一覧
Podでセンター試験 数学I・A (Podシリーズ) 西岡 康夫
参考書・赤本・専門書・医学書、予備校テキスト・塾テキスト・教材を30万点以上出品しています。
◎希学園6年 志望校別特訓 算数 第1期 第2期
セルフヘルプ・グループ
※上記クリック後、「半角または全角スペース+検索したいワード」を追加することで、予備校名や出版社名、講師名等で絞れます。
塾講師オリジナル数学解説 全問動画付 沖縄 公立高校入試 2022-24 過去問
例)
グレーゾーンから考える 相続・贈与税の土地適正評価の実務 (新版) [単行本] 風岡 範哉
「#ブックスドリーム出品一覧駿台」
真宗民俗史論 [単行本] 蒲池 勢至
「#ブックスドリーム出品一覧旺文社」
中学への算数 12冊 vol.26
「#ブックスドリーム出品一覧四谷大塚小6算数」
塾講師オリジナル数学解説 全問動画付 愛媛 公立高校入試 2022-24 過去問
語学+参考書 Twenty Lectures on Algorithmic Game Theory
中学受験 暗記カード【4年上 社会・理科 11-14回】組分けテスト対策 予シリ
【発送予定日について】
やさしいインプラント治療
正午12時まで(日曜日は午前9時まで)のご注文は当日に発送いたします。正午12時(日曜日は午前9時)以降のご注文は翌日に発送いたします(土曜日・日曜日・祝日も発送しています)。
和歌山県の数学科過去問 2017年度版 (教員採用試験「過去問」シリ-ズ) 協同教育研究会
※土曜日・祝日も正午12時までのご注文は当日に発送いたします。
10年間スーパー過去問301栄光学園中学校 平成28年度用
※年末年始(12/31〜1/3)は除きます。
Current Medical Diagnosis & Treatment 2020 [ペーパーバック] Papadakis, Maxine A., M.D.、 McPhee, Stephen J., M.D.; Rabow, Michael W., M.D.
塾講師オリジナル数学解説 全問動画付 和歌山公立高校入試 2022-24 過去問
(例)
【小5】2023年度版国語カラーテスト【光村図書】【光文書院】
・月曜0時〜12時までのご注文:月曜日に発送
鹿児島県 公立高校 入試 過去問 10冊セット(過去問12年分)
・月曜12時〜24時までのご注文:火曜日に発送
浜学園 小6 第599〜609回 公開学力テスト 国語/算数/理科/社会 テスト計11回分セット 2023 ☆ 066M2D
・土曜0時〜12時までのご注文:土曜日に発送
鉄緑会 中2 英語基礎講座 INTERMEDIATE 第1/2部/問題集 テキスト通年セット 2019 計4冊 CD12枚付 ☆ 000L0D
・土曜12時〜24時のご注文:日曜日に発送
画像診断 12年6月号 (32-7)
・日曜0時〜9時までのご注文:日曜日に発送
塾講師オリジナル数学解説 全問動画付 関西学院 2022~24 高校入試 過去問
・日曜9時〜24時のご注文:月曜日に発送
栄養調理六法 平成19年版 栄養調理関係法令研究会
法と立法と自由I ハイエク全集 1-8 新版 F.A. ハイエク
【送付方法について】
塾講師オリジナル数学解説 全問動画付 山口 公立高校入試 2022~24 過去問
ネコポス、宅配便またはレターパックでの発送となります。
London's West End: Creating the Pleasure District, 1800-1914 [ハードカバー] McWilliam, Rohan
塾講師オリジナル数学解説 全問動画付 岡山 公立高校入試 2022-24 過去問
東北地方・新潟県・北海道・沖縄県・離島以外は、発送翌日に到着します。
青本 早稲田大学 4冊セット 社会学部 商学部 文化構想学部 法学部
東北地方・新潟県・北海道・沖縄県・離島は、発送後2日での到着となります。
【裁断済み】オックスフォード生理学
中国言語生活状況報告書 2018 第4巻/中国書店/中国教育部言語文字信息管理司(単行本)
語学+参考書 Trees (Springer Monographs in Mathematics)
商品説明と著しく異なる点があった場合や異なる商品が届いた場合は、到着後30日間は無条件で着払いでご返品後に返金させていただきます。取引メッセージにてご連絡ください。
fendo-13-846154-g007.jpg
商品説明に誤りがある場合は、無条件で弊社送料負担で商品到着後30日間返品を承ります。
民事書記官事務の解説―第一審訴訟記録に基づいて 裁判所職員総合研修所
MFCプログラミング (アスキーアジソンウェスレイシリーズ) Alan R.Feuer、 ロングテール; 長尾 高弘
【最短翌日到着】
頭・頸部の筋の形と位置: 立体的イメージングのために
正午12時まで(日曜日は午前9時まで)の注文は当日発送(土日祝も発送)。関東・関西・中部・中国・四国・九州地方は翌日お届け、東北地方・新潟県・北海道・沖縄県は翌々日にお届けします。
画像検査診断用語事典―サイン・画像所見・症候群・検査用語 [単行本] 楢林勇; 中尾宣夫
Modern Military Strategy [ペーパーバック] Sloan, Elinor C.
【インボイス制度対応済み】
眼鏡&コンタクトレンズの合わせかた: 67の屈折矯正で知る・学ぶ・鍛える (眼科ケア2013年夏季増刊) [単行本] 佐野 研二; 河賀 友紀
当社ではインボイス制度に対応した適格請求書発行事業者番号(通称:T番号・登録番号)を印字した納品書(明細書)を商品に同梱してお送りしております。こちらをご利用いただくことで、税務申告時や確定申告時に消費税額控除を受けることが可能になります。
古文全天候バイブル 吉川 栄治
憲法I [第3版] 法律学全集3 清宮 四郎
ご満足のいく取引となるよう精一杯対応させていただきます。
Principles of Exercise Testing and Interpretation,Wasserman MD PhD,Karlman、 Hansen MD,James E.、 Sue MD,Darryl Y.、 Stringer MD,William W.、 Sietsema MD,Kathy E.、 Sun MD,Xing-Guo; Whipp PhD DSc,Brian J
Photoshop 4.0Jびっくりロゴデザイン
※下記に商品説明およびコンディション詳細、出荷予定・配送方法・お届けまでの期間について記載しています。ご確認の上ご購入ください。
平成27年版 体系別 司法試験・予備試験 短答 過去問集 刑法 スクール東京; 豊彦,成川
ハンセン病違憲国賠裁判全史 [単行本] ハンセン病違憲国賠裁判全史編集委員会
■商品名■
膀胱の手術 (新Urologic Surgeryシリーズ 2) 中川 昌之
Brock微生物学
語学+参考書 Constructionalization and Constructional Changes (Oxford Studies in Diachronic and Historical Linguistics)
みんなが欲しかった 簿記の教科書 日商2級 工業簿記 第7版対応DVD (TAC出版) (みんなが欲しかったシリーズ) TAC出版編集部
■出版社■
外国人技能実習生受入れ実践ガイド――入管手続と協同組合作り [単行本(ソフトカバー)] 岸本 和博
オーム社
口腔病理カラ-アトラス 石川梧朗
スマートナース 11巻3号
■著者■
エッセンシャル遺伝学・ゲノム科学(原著第7版)
Brock
数学1・A2・B (2004) (河合塾シリーズ)
語学+参考書 Mechanics: Volume 1
■発行年■
食品学各論(第3版): 食品素材と加工学の基礎を学ぶ 瀬口 正晴; 八田 一
2003/04/15
テキスト裁断済み 河合塾 2019・2020 冬期講習 東大物理 苑田尚之先生
アンズワールド ディズニー英語システムDWE
■ISBN10■
Attachment in Psychotherapy [ペーパーバック] Wallin,David J.
4274024881
Lucknow: The City of Heritage & Culture: a Walk Through History [ハードカバー] Varshney,Vipul B.; Jaiswal,Ajaish
歯科衛生士臨床のすべて―経験から学ぶ臨床 (quintessence books) AntonellaTani Botticelli、 浩,岡本、 愉,関野、 泰子,竹内; 由香里,星野
■ISBN13■
金沢医科大学 2020年度 (医学部入試問題と解答) [単行本] みすず学苑中央教育研究所
9784274024887
安全な内視鏡外科手術のための基本手技トレーニング [単行本] 橋爪誠; 富川盛雅
語学+参考書 Recursive Methods in Economic Dynamics
■コンディションランク■
芝浦工業大学柏高等学校 2020年度用 (高校別入試過去問題シリーズ C9) 東京学参 編集部
可
HOW TO 審美と歯周外科 (クリニカル・テクニック・シリーズ) [単行本] 伊藤 公一
診療画像検査法X線撮影法
コンディションランク説明
間脳下垂体 (脳神経外科エキスパ-ト) 佐伯直勝
ほぼ新品:未使用に近い状態の商品
ペインクリニックに必要な局所解剖 麻酔科診療プラクティス (12) 真弓,高崎
非常に良い:傷や汚れが少なくきれいな状態の商品
整形外科のMRI 秀繁,守屋; 宏,北原
良い:多少の傷や汚れがあるが、概ね良好な状態の商品(中古品として並の状態の商品)
国際私法年報 第21号(2019) [単行本] 村上愛 、 駒田 泰土、 阿部 耕一、 小塚 荘一郎、 中村 知里、 金 美和、 不破 茂; 国際私法学会
可:傷や汚れが目立つものの、使用には問題ない状態の商品
ショック管理 2021-’22 (救急・集中治療33巻3号) [単行本] 垣花泰之
大学への数学入試の軌跡東工大10年間・理科大3年間 2002 (軌跡シリーズ)
■コンディション詳細■
SAPIX 小3 サピックス 算数基礎力トレーニング 【計12回分】 通年セット 2020 ☆ 035M2D
当商品はコンディション「可」の商品となります。多少の書き込みが有る場合や使用感、傷み、汚れ、記名・押印の消し跡・切り取り跡、箱・カバー欠品などがある場合もございますが、使用には問題のない状態です。水濡れ防止梱包の上、迅速丁寧に発送させていただきます。
西大和学園中の理科20年 2023年度受験用 赤本 1915 (難関中学シリーズ)
小児歯科学 赤坂 守人
SAPIX サピックス 6年 社会
■当社の出品一覧↓■
浜学園 小6 第563〜573回 公開学力テスト 国語/算数/理科/社会 テスト計11回分セット 2020 ☆ 057M2D
#ブックスドリーム出品一覧
Podでセンター試験 数学I・A (Podシリーズ) 西岡 康夫
参考書・赤本・専門書・医学書、予備校テキスト・塾テキスト・教材を30万点以上出品しています。
◎希学園6年 志望校別特訓 算数 第1期 第2期
セルフヘルプ・グループ
※上記クリック後、「半角または全角スペース+検索したいワード」を追加することで、予備校名や出版社名、講師名等で絞れます。
塾講師オリジナル数学解説 全問動画付 沖縄 公立高校入試 2022-24 過去問
例)
グレーゾーンから考える 相続・贈与税の土地適正評価の実務 (新版) [単行本] 風岡 範哉
「#ブックスドリーム出品一覧駿台」
真宗民俗史論 [単行本] 蒲池 勢至
「#ブックスドリーム出品一覧旺文社」
中学への算数 12冊 vol.26
「#ブックスドリーム出品一覧四谷大塚小6算数」
塾講師オリジナル数学解説 全問動画付 愛媛 公立高校入試 2022-24 過去問
語学+参考書 Twenty Lectures on Algorithmic Game Theory
中学受験 暗記カード【4年上 社会・理科 11-14回】組分けテスト対策 予シリ
【発送予定日について】
やさしいインプラント治療
正午12時まで(日曜日は午前9時まで)のご注文は当日に発送いたします。正午12時(日曜日は午前9時)以降のご注文は翌日に発送いたします(土曜日・日曜日・祝日も発送しています)。
和歌山県の数学科過去問 2017年度版 (教員採用試験「過去問」シリ-ズ) 協同教育研究会
※土曜日・祝日も正午12時までのご注文は当日に発送いたします。
10年間スーパー過去問301栄光学園中学校 平成28年度用
※年末年始(12/31〜1/3)は除きます。
Current Medical Diagnosis & Treatment 2020 [ペーパーバック] Papadakis, Maxine A., M.D.、 McPhee, Stephen J., M.D.; Rabow, Michael W., M.D.
塾講師オリジナル数学解説 全問動画付 和歌山公立高校入試 2022-24 過去問
(例)
【小5】2023年度版国語カラーテスト【光村図書】【光文書院】
・月曜0時〜12時までのご注文:月曜日に発送
鹿児島県 公立高校 入試 過去問 10冊セット(過去問12年分)
・月曜12時〜24時までのご注文:火曜日に発送
浜学園 小6 第599〜609回 公開学力テスト 国語/算数/理科/社会 テスト計11回分セット 2023 ☆ 066M2D
・土曜0時〜12時までのご注文:土曜日に発送
鉄緑会 中2 英語基礎講座 INTERMEDIATE 第1/2部/問題集 テキスト通年セット 2019 計4冊 CD12枚付 ☆ 000L0D
・土曜12時〜24時のご注文:日曜日に発送
画像診断 12年6月号 (32-7)
・日曜0時〜9時までのご注文:日曜日に発送
塾講師オリジナル数学解説 全問動画付 関西学院 2022~24 高校入試 過去問
・日曜9時〜24時のご注文:月曜日に発送
栄養調理六法 平成19年版 栄養調理関係法令研究会
法と立法と自由I ハイエク全集 1-8 新版 F.A. ハイエク
【送付方法について】
塾講師オリジナル数学解説 全問動画付 山口 公立高校入試 2022~24 過去問
ネコポス、宅配便またはレターパックでの発送となります。
London's West End: Creating the Pleasure District, 1800-1914 [ハードカバー] McWilliam, Rohan
塾講師オリジナル数学解説 全問動画付 岡山 公立高校入試 2022-24 過去問
東北地方・新潟県・北海道・沖縄県・離島以外は、発送翌日に到着します。
青本 早稲田大学 4冊セット 社会学部 商学部 文化構想学部 法学部
東北地方・新潟県・北海道・沖縄県・離島は、発送後2日での到着となります。
【裁断済み】オックスフォード生理学
中国言語生活状況報告書 2018 第4巻/中国書店/中国教育部言語文字信息管理司(単行本)
語学+参考書 Trees (Springer Monographs in Mathematics)
商品説明と著しく異なる点があった場合や異なる商品が届いた場合は、到着後30日間は無条件で着払いでご返品後に返金させていただきます。取引メッセージにてご連絡ください。
商品情報
。北海道農業の地帯構成と構造変動。塾講師オリジナル数学解説 全問動画付 岐阜 公立高校入試 2022-24 過去問。和角の古文頻出問題 和角仁。【裁断済み】ROSS 組織学 7版。子宮内膜症・子宮腺筋症こんなときどうする?―難易度の高い手術を安全,確実に行うための基本手技マ (OGS NOW No. 12) 櫻木 範明。江户川学園取手小学校 2022年受験実力養成問題シート1〜6集。子供の英語教材 【美品】 月刊ポピー。【★最新★2024受験】【聖光対策(算数)】Sapix6年 土曜特訓。English A: Literature (Oxford Ib Diploma Programme) [ペーパーバック] Androulaki, Anna; Whitted, Brent。サピックス 2023年度 6年生 7月度入室組分けテスト 小6 SAPIX最新版。アトラス骨・関節画像診断 6。IELTSブリティッシュ・カウンシル公認問題集 最新刊5冊セット 台湾版表紙。塾講師オリジナル数学解説 全問動画付!! 巣鴨 2022-24 高校入試 過去問。農林水産研究文献解題 No.30 農林水産技術会議事務局。【値下げ/在庫処分①】セブンプラスイングリッシュ 英語教材。英文を正しく読む50講: 解釈から訳出へ 倉谷 直臣。Webサービス入門: Javaを使って覚える簡単SOAP、WSDL、UDDIプログラミング。数学図形問題の探求。東邦大学。重症心身障害児の栄養管理マニュアル 中村博志。塾講師オリジナル数学解説 全問動画付 山形 公立高校入試 2022-24 過去問。長野県立こども病院方式 超低出生体重児の管理マニュアルベストセラーランキングです
近くの売り場の商品
カスタマーレビュー
オススメ度 4.7点
現在、3807件のレビューが投稿されています。

![伴侶動物の麻酔テクニック [単行本(ソフトカバー)] Amanda M. Shelby、 Carolyn M. McKune; 佐野忠士](https://img.fril.jp/img/706306455/l/2352609108.jpg)

![真宗教義学原論 2 (信楽峻麿著作集 第7巻) [単行本] 信楽 峻麿](https://img.fril.jp/img/713865545/l/2384890525.jpg)










